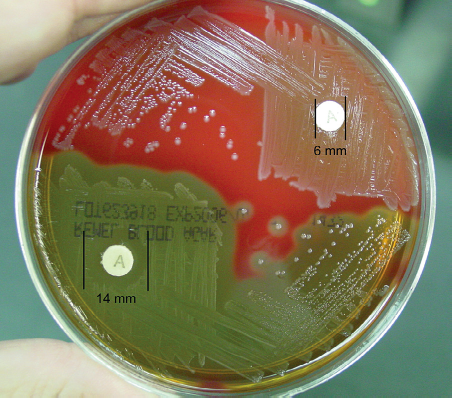
تست حساسیت به اپتوچین

مقدمه
جهت افتراق استرپتوکوکوس پنومونیه از سایر استرپتوکوکهای ویریدانس (viridans streptococci) از تست حساسیت به اپتوچین، تست bile solubility، تست واکنش با یک پروب DNA خاص یا تست تشخیص پلیساکاریدهای کپسولی (capsular polysaccharide) خاص گونه، استفاده میشود. امروزه اکثر آزمایشگاههای میکروبیولوژی بالینی از تست حساسیت اپتوچین استفاده میکنند.
اگرچه تست حساسیت به اپتوچین برای اولین بار برای افتراق پنوموکوکها (Pneumococci) از سایر استرپتوکوکهای α-همولیتیک (α-hemolytic) در سال 1915 ارائه شد، اما این تست تقریباً تا اواسط دهه 1950 توسط آزمایشگاهها استفاده نشد.
اپتوچین یا اتیلهیدروکوپرین هیدروکلراید (ethylhydrocupreine hydrochloride) یک ماده شیمیایی و کاملاً قابل حل در آب است. اپتوچین در افتراق استرپتوکوک پنومونیه از استرپتوکوک آلفا همولیتیک که معمولاً به این ماده شیمیایی حساس است، مفید است. سایر گونههای استرپتوکوک آلفا همولیتیک به اپتوچین مقاوم هستند. این آزمایش تعیین میکند که آیا باکتری نسبت به اپتوچین حساس یا مقاوم است.
اپتوچین به طور گسترده به شکل دیسکهای کاغذ صافی دارای اتیلهیدروکوپرین هیدروکلراید، استفاده میشود که مستقیماً روی پلیتهای تلقیح شده قبل از انکوباسیون قرار میگیرند. تست اپتوچین نسبت به تست Bile solubility زمان کمتری جهت اجرا نیاز دارد.
هدف تست حساسیت به اپتوچین
تعیین اثر اپتوچین بر روی ارگانیسم مورد آزمایش.

اصول تست حساسیت به اپتوچین
جهت شناسایی مثبت استرپتوکوک پنومونیه باید یک ناحیه عدم رشد، به طور مشخص در اطراف دیسک ایجاد شود. سایر استرپتوکوکهای آلفا همولیتیک این ناحیه را در حضور اپتوچین ایجاد نمیکنند. این ماده شیمیایی شکنندگی غشای سلولی باکتری را آزمایش میکند و به دلیل تغییرات کشش سطحی باعث لیز (lyse) شدن استرپتوکوکوس پنومونیه میشود.
روش تست حساسیت به اپتوچین
- با استفاده از یک سوزن کشت، سه تا چهار کلنی از ارگانیسم آلفا همولیتیک که به خوبی ایزوله شدهاند را انتخاب کنید. همچنین میتوان از کشت 18 تا 24 ساعته از ارگانیسم ایزوله شده برای تست استفاده کرد.
- کلنی کشت شده را دورن پلیت تریپتیک سوی آگار (TSA) یا بلاد آگار گوسفندی (sheep blood agar) 5 درصد به صورت کشت خطی، تلقیح کنید.
توجه: استفاده از محیطهای کشت غیر از TSA یا بلاد آگار گوسفندی توصیه نمیشود، زیرا ممکن است منجر به شناسایی نادرست ارگانیسم شود.
- با استفاده از پنس استریل، یک دیسک اپتوچین را روی سطح تلقیح شده آگار قرار دهید.
- دیسک را به آرامی با یک پنس استریل فشار دهید تا دیسک محکم به سطح آگار بچسبد.
- پلیت را در دمای 2 ±35 درجه سانتیگراد به مدت 18 تا 24 ساعت با دیاکسید کربن 5 تا10 درصد انکوبه کنید.
- اگر ناحیه عدم رشد وجود دارد، قطر آن را با خط کش یا کولیس میلیمتری اندازهگیری کنید.
تفسیر نتایج تست حساسیت به اپتوچین
اگر کلنی آلفا همولیتیک ناحیه عدم رشد با قطر 14 میلیمتر یا بیشتر در اطراف دیسک ایجاد کند، میتوان ارگانیسم را به عنوان استافیلوکوکوس پنومونیه شناسایی کرد. ارگانیسمهایی که ناحیه کوچکتر تولید میکنند باید با bile solubility آزمایش شوند. ارگانیسمهایی با اندازه ناحیه مشکوک (6-14 میلیمتر) در اطراف دیسک، تنها در صورتی که نتیجه تست bile solubility مثبت باشد، باید به عنوان پنوموکوک شناسایی شوند.
تست مثبت: ناحیه عدم رشد با قطر 14 میلیمتر یا بیشتر در اطراف دیسک 6 میلیمتری.
تست منفی: بدون ناحیه عدم رشد یا وجود ناحیه عدم رشد با قطر کمتر از 14 میلیمتر.
کنترل کیفیت برای تست حساسیت به اپتوچین
مثبت: استاندارد Streptococcus pneumoniae (ATCC ® 6305) و S. pneumoniae (ATCC 49619)
منفی: استاندارد Streptococcus pyogenes (ATCC ® 19615) و S. mitis (ATCC 49456)
موارد استفاده
اپتوچین پنوموکوکها را لیز میکند (تست مثبت)، اما آلفا استرپتوکوکها مقاوم هستند (آزمایش منفی). بنابراین اپتوچین به شناسایی این ارگانیسمها کمک میکند.
محدودیتهای تست حساسیت اپتوچین
- محققان نشان دادهاند که سایر سویههای استرپتوکوک آلفا همولیتیک ممکن است حساسیت جزئی به اپتوچین نشان دهند.
- تست حساسیت به اپتوچین فقط یک آزمایش احتمالی است. توصیه میشود برای شناسایی کامل آزمایشات بیوشیمیایی بیشتری انجام شود.
- بسیاری از ارگانیسمها نواحی مشخصی را در محیطهای کشت غیر از بلاد آگار گوسفندی یا TSA ایجاد نمیکنند و به آزمایشهای بیشتری برای شناسایی آنها به عنوان pneumoniae نیاز دارند.
- کلنیهای ایزولهشده استافیلوکوکوس پنومونیه باید با حضور CO2 انکوبه شوند، زیرا برخی از کلنیها رشد هوازی ضعیفی دارند یا اصلاً رشد نمیکنند.
مطالعات بیشتر:
تست سولفید هیدروژن (Hydrogen Sulfide)
مترجم: فاطمه فریادرس




سلام
ببخشید میشه بگید سریع ترین و ساده ترین و قطعی ترین روش تشخیص ازمایشگاهی استرپتوکوکوس پنومونیه چیه؟
1. تست آنتیژنی ادرار
این تست برای شناسایی سریع آنتیژن پلیساکارید کپسولی خاص S. pneumoniae در نمونههای ادرار بیماران استفاده میشود. این روش مزایای زیر را دارد:
سرعت بالا: نتایج ظرف چند دقیقه قابل دسترس هستند.
سادگی انجام: نیاز به تجهیزات پیچیده ندارد و به راحتی قابل اجرا است.
حساسیت و اختصاصیت: دارای حساسیت و اختصاصیت مناسبی برای تشخیص عفونتهای ناشی از S. pneumoniae است، هرچند که در برخی موارد ممکن است به دلیل وجود سویههایی با آنتیژنهای مشابه، نتایج کاذب مثبت را نیز نشان دهد.
2. کشت خون یا مایعات بدن
کشت باکتریایی استاندارد یکی دیگر از روشهای مؤثر برای تشخیص دقیق استرپتوکوکوس پنومونیه است:
دقت بالا: کشت میتواند باکتریها را به صورت قطعی شناسایی کند.
اختصاصیت: امکان تعیین نوع دقیق باکتری و حساسیت آن به آنتیبیوتیکها.
زمانبر: نتایج کشت معمولاً نیاز به 24 تا 48 ساعت زمان دارد.
3. PCR و تکنیکهای مولکولی
روشهای مولکولی مانند PCR برای شناسایی دقیق و سریع DNA یا RNA خاص از S. pneumoniae استفاده میشوند:
سرعت بالا: نتایج میتوانند در عرض چند ساعت به دست آیند.
حساسیت و دقت بسیار بالا: قادر به تشخیص مقادیر بسیار کم DNA باکتریایی حتی در نمونههایی با بار باکتریایی پایین.
پیچیدگی فنی: نیاز به تجهیزات خاص و تخصص فنی برای اجرا و تفسیر نتایج.
سلام اصول تست حساسیت به اپتو چین نوشتید استافیلوکوکوس پنومونیه اشتباه است .سوالم اپتوچین توجارشمعی انکوبه بشه ؟ ۲.nacl6.5درصدد بدون نوترین براث میشه درست کرد؟دستور ساخت رو بی زحمت میفرستید ؟؟
از محیط TSA به همراه 5% خون دفیبیرنه گوسفندی در جار بی هوازی با شمع ویا بهتر است گازپک نوع C استفاده شود
نام آزمایشی که درآن این ،باکتری استر پتوکوکوس پنومیه رامشخص می کند چیست؟
با سلام،
با نام کشت خون شناخته میشود.
در مرحله اول خون گرفته شده از فرد در محیط کشت مخصوص کشت داده میشود. بعد از گذشت 24 ساعت به محیط های افتراقی برای تشخیص و مشاهده ی سویه ی مورد نظر منتقل میشود.